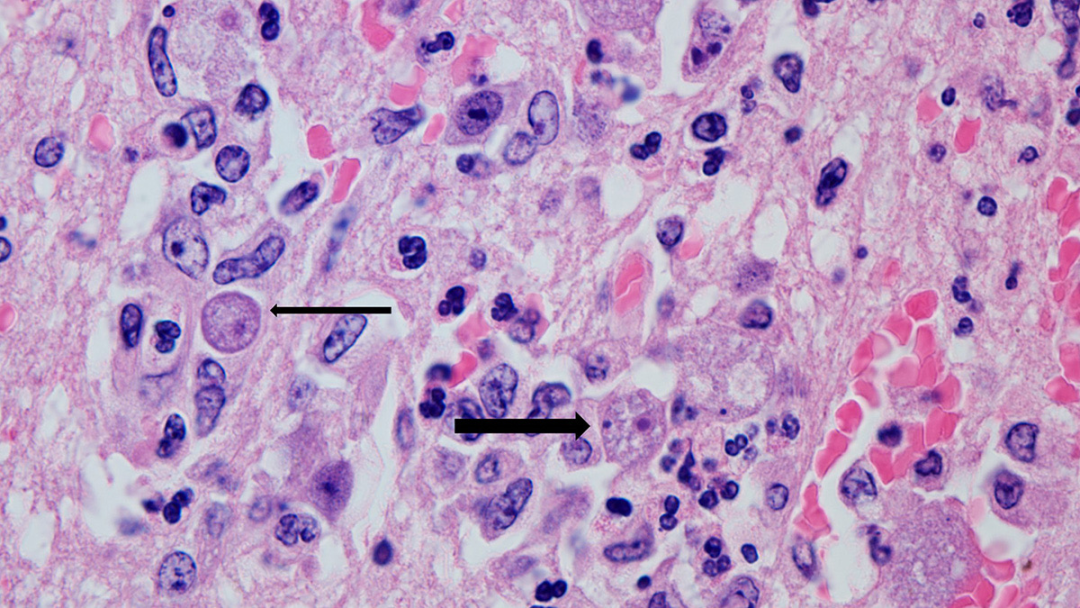
家长注意！儿童玩水后感染“食脑虫”，专家提醒

最近,来自福建和安徽的两位家长分别在网上发帖称,自己的孩子在玩水后感染了“食脑虫”,情况十分危急,这引起了很多家长的担心。
“食脑虫”到底是什么?正常游水嬉戏容易中招吗?家长应该采取哪些措施,才能有效避免孩子们遭遇这类风险呢?夏季玩水警惕“食脑虫”,避免高风险暴露!
“食脑虫”是什么?
会对人体造成哪些损害?
“食脑虫”并不是真的虫子,而是一类分布于自然界中的单细胞生物阿米巴原虫。根据患儿家长在网络上发布的消息,近期受到关注的两例阿米巴原虫感染病例,分别感染了“福氏耐格里阿米巴原虫”和“狒狒巴拉姆希阿米巴原虫”。
首都医科大学附属北京友谊医院北京热带医学研究所主任医师王磊介绍,目前被称为“食脑虫”的有三种感染的病原体:福氏耐格里阿米巴(Naeglena fowleri)、狒狒巴拉姆希阿米巴(Balamuthia mandrillaris)和双核匀变虫(Sappinia diploidea),感染后容易对人体中枢神经系统造成损害。
 △箭头指示为脑脊液中福氏耐格里属阿米巴
△箭头指示为脑脊液中福氏耐格里属阿米巴
△箭头指示为脑组织中狒狒巴卡西姆阿米巴滋养体
△箭头指示为脑组织中狒狒巴卡西姆阿米巴滋养体
目前这三种阿米巴原虫在全世界范围内报告病例比较少,但会对人体造成皮肤性损害,通过破溃的皮肤进入人体后,在破溃局部形成肉芽肿性改变。
此外,阿米巴原虫可以侵入到中枢神经系统,表现为患者出现间断或者持续性抽搐、昏睡昏迷,出现以颅内高压为表现的恶心、呕吐、头疼,大约1~2周后就会造成不可逆转的神经系统病变。
2022年,浙江大学医学院附属儿童医院感染科曾收治了一例阿米巴原虫感染患儿,经过两个月左右的治疗,患儿才脱离了生命危险。
浙江大学医学院附属儿童医院感染科主任黄丽素曾参与过这次救治,她坦言,目前幼儿感染阿米巴原虫在治疗药物和方案上还缺乏成熟手段。现在能做的只是根据患者情况,通过多种药物联合作用、控制颅内压力、手术等综合手段积极挽救患儿生命。
 △福氏阿米巴病患者脑组织中的免疫荧光检测(阿米巴呈绿色)
△福氏阿米巴病患者脑组织中的免疫荧光检测(阿米巴呈绿色)
避免“食脑虫”感染
夏日戏水该如何做好预防?
根据家长叙述,近期感染“食脑虫”的两个孩子均是玩水后出现症状。夏日戏水真的这么危险吗?
据专家介绍,阿米巴原虫主要分布在自然水体和土壤等野外环境中,如湖泊、河流、温泉,还有不干净的泳池、阴沟水、潮湿泥土、腐烂植物,尤其在温暖环境下更容易滋生。
黄丽素解释,人们游泳或玩水时,可能会导致含虫水体进入人体,尤其是通过鼻腔进入人体的阿米巴原虫可通过嗅神经直接抵达大脑,几乎绕过人体免疫“哨卡”,留给免疫系统反应的时间很短,这就造成了疾病的快速发展。
 △福氏耐格里属阿米巴的感染致病示意图
△福氏耐格里属阿米巴的感染致病示意图
那么,如何做好预防才能避免“食脑虫”感染?专家建议,必须防范高风险暴露的情况,比如夏季不应在野外水体里游泳、洗澡。
王磊解释,没有经过消杀的自然水体里有很多可致病的微生物,不只是阿米巴原虫,其他病原体也可能引起多种感染。要避免在不洁净的水体中潜水、跳水,以免增加鼻腔进水风险。同时,游泳戏水后可以用清洁的饮用水清洁鼻腔口腔等。
此外,在自身皮肤破溃的情况下,尽量不要进入自然水体,或是在进入自然水体前要做好破溃皮肤的处理工作,避免阿米巴原虫通过伤口进入人体。
如果需要进入自然水体,要使用鼻夹,避免搅动水体底层的沉积物质。如果发现有皮肤破溃,或是有鼻夹脱落、呛水的情况,一定要及时和医疗机构人员联系,及时检测。
①凡本网注明“来源:福州新闻网”的所有文字、图片和视频,版权均属福州新闻网所有,任何媒体、网站或个人未经本网协议授权不得转载、链接、转贴或以其他方式复制发表。已经被本网协议授权的媒体、网站,在下载使用时必须注明“来源:福州新闻网”,违者本网将依法追究责任。
②本网未注明“来源:福州新闻网”的文/图等稿件均为转载稿,本网转载出于传递更多信息之目的,并不意味着赞同其观点或证实其内容的真实性。如其他媒体、网站或个人从本网下载使用,必须保留本网注明的“来源”,并自负版权等法律责任。如擅自篡改为“来源:福州新闻网”,本网将依法追究责任。如对文章内容有疑议,请及时与我们联系。
③ 如本网转载涉及版权等问题,请作者在两周内速来电或来函与福州新闻网联系。









